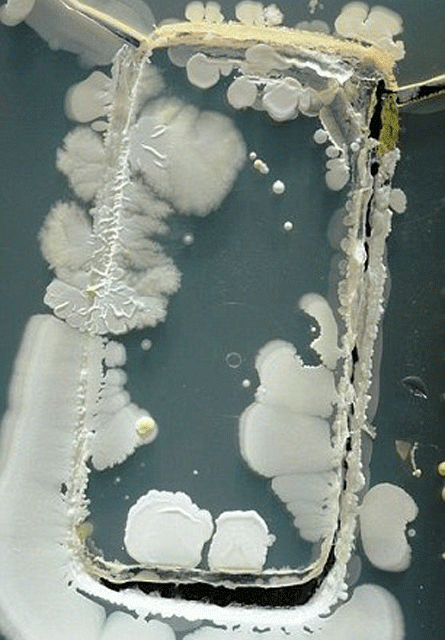
Les bactéries de votre téléphone intelligent

ARTICLES
EN VEDETTE
27 mars 2026
WKND.FM fait peau neuve27 mars 2026
Les meilleures émissions musicales sont à WKN…27 mars 2026
WKND lance sa campagne numérique du printemps12 mars 2026
Trois changements à WKND 91,929 avril 2026
Écouter WKND au bureau n’a jamais été aussi s…ARTICLES
TOUS LES ARTICLES
17 janvier 2015
Nouveau clip de Maroon 516 janvier 2015
Les trouvailles de François Charron au CES 20…16 janvier 2015
Les bactéries de votre téléphone intelligent16 janvier 2015
Des croyances sur l'alcool démystifiées16 janvier 2015
Une femme a dépensé 300 000$ pour ressembler …16 janvier 2015
Eugénie Bouchard pose pour Nike16 janvier 2015
Suggestion vino du Retour16 janvier 2015
Le Ti-Mé Show16 janvier 2015
Le chocolat chaud "La Reine des Neiges"15 janvier 2015
13 raisons pour lesquelles Target ne manquera…15 janvier 2015
Les tendances alimentaires naturelle de 201515 janvier 2015
L'agenda WKND du 15 janvier